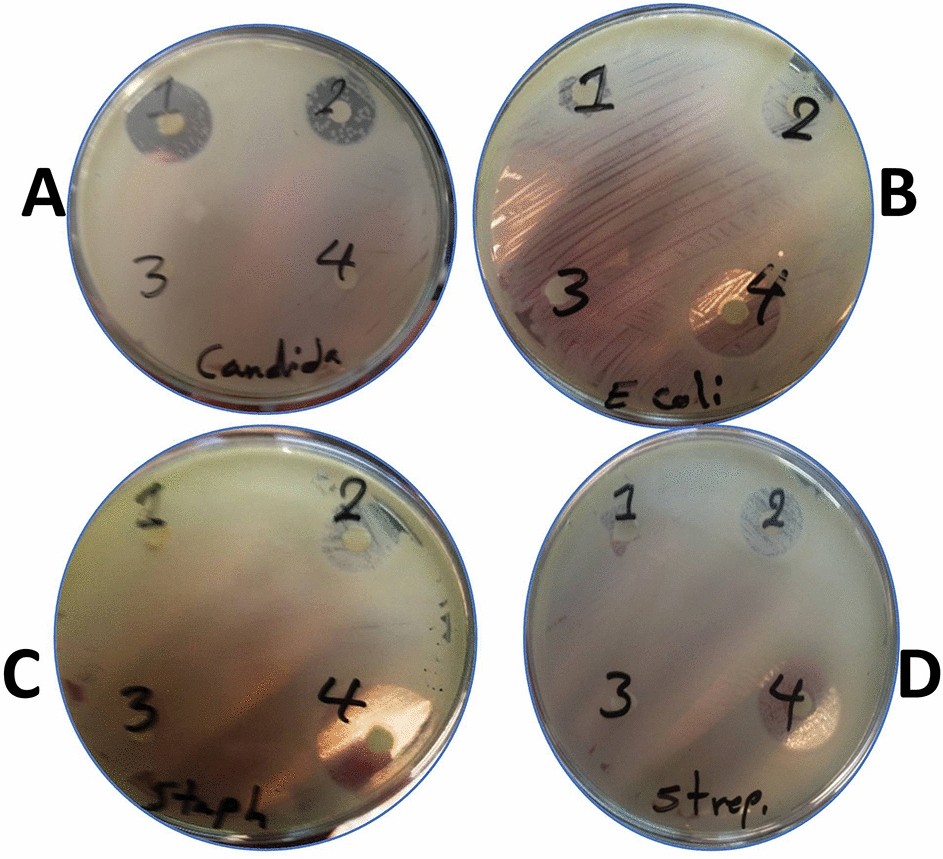
Figure 5

Figure 5
Antimicrobial activity of Nile Tilapia fish scale-based collagen nanoparticles prepared by ethanol showing clear zones of bacterial inhibition against Candida albicans (C. albicans) (A), Escherichia coli (E. coli) (B), Staphylococcus aureus (S. aureus) (C) Streptococcus mutans (S. mutans) (D) using 5 μg (1) and 10 μg (2). Antimicrobial activity of Nile Tilapia fish scale-based collagen nanoparticles prepared by acetone showing clear zones of bacterial inhibition against S. aureus, S. mutans, E. coli, and C. albicans using 5 μg (3) and 10 μg (4).